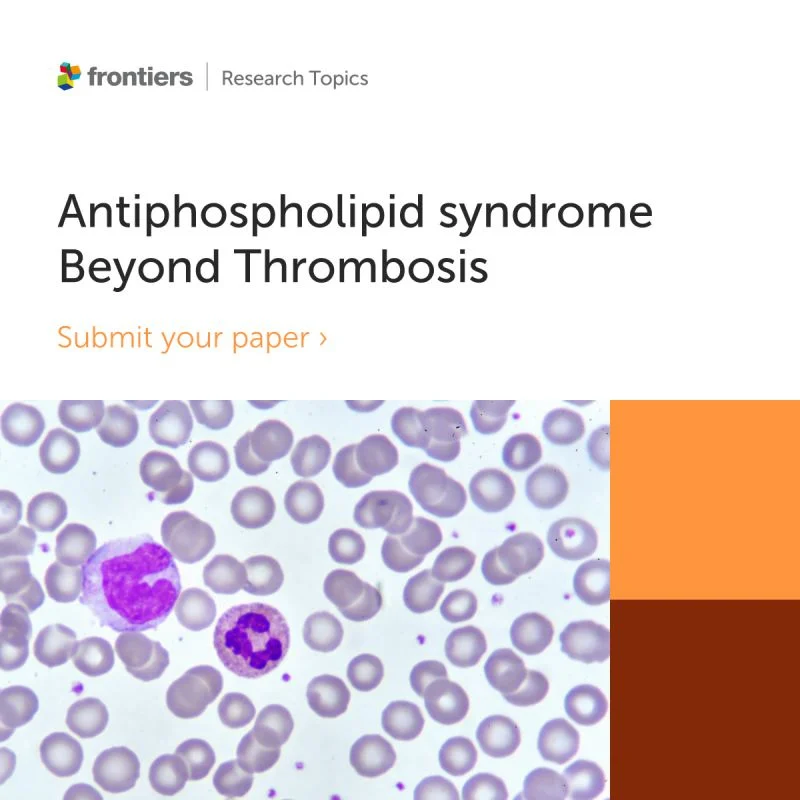
Frontiers-Immunology

Call for Papers Antiphospholipid Syndrome Beyond Thrombosis – Frontiers-Immunology
Frontiers-Immunology shared a post on LinkedIn:
“Call for Papers: Antiphospholipid syndrome – beyond thrombosis (Frontiers in Lupus)
‘Antiphospholipid syndrome – beyond thrombosis’ is now welcoming submissions that push APS research past the classic ‘clotting-only’ framing – especially where APS intersects with lupus.
APS is defined by thrombotic risk in the presence of antiphospholipid antibodies (aPL). But newer work suggests the biology is not purely coagulation-driven. Complement activation, immune–coagulation cross-talk, and organ-specific manifestations (including pregnancy morbidity and possible inflammatory contributors to APS nephropathy) point to mechanisms that may matter for outcomes — and for treatment choices.
This Research Topic focuses on what we need to understand next:
- Inflammation and complement activation as drivers of APS manifestations
- Therapies beyond long-term anticoagulation (including approaches for treatment-resistant disease, high-risk aPL patterns, or arterial thrombosis)
- Novel biomarkers for APS diagnosis and risk stratification
- Multidisciplinary strategies for obstetric APS management
- Implications of the 2023 ACR/EULAR classification criteria for diagnosis and treatment
- Genetic and epigenetic factors shaping APS pathogenesis and progression
- Risk of SLE development in patients with primary APS
- APS emergence in SLE patients who were initially serologically negative
If your work helps clarify how thrombotic and inflammatory pathways interact in APS, and what that means for patients, this collection is a strong fit, including original research, reviews, and case analyses.
Manuscript Summary deadline (optional): 1 February 2026
Manuscript deadline: 22 May 2026
Led by: Magdalena Celińska-Lowenhoff, Teresa Iwaniec, Chaim Putterman
In: Frontiers in Lupus
Submit here.”
Stay updated on all scientific advances in the field of fertility with Fertility News.
-
Apr 30, 2026, 18:45AI in Ultrasound Follicular Monitoring Moves Toward Clinical Decision Support – RBMO
-
Apr 30, 2026, 11:42ASRM Encourages Registration for Conference on Practice Growth and Innovation
-
Apr 30, 2026, 11:26ESHRE and ALPHA Launch Global Survey to Update ART Laboratory KPIs
-
Apr 30, 2026, 11:10Susanne Johnson: Advanced Gynaecology Ultrasound Course Day 2
-
Apr 30, 2026, 11:02Platelets Reduce Oxidative Stress Damage in Human Endometrial Stromal Cells in Vitro – RBMO
-
Apr 30, 2026, 10:57GREEG Day 2026: Elevate Your Ultrasound Expertise – GREEG
-
Apr 30, 2026, 10:49Up to Two-Thirds of Elite Female Athletes Experience Irregular Periods – Fertility Plus
-
Apr 30, 2026, 10:47Applications for the ESHRE5 Young Ambassadors 2026 are Still OPEN, But Not for Long! – ESHRE
-
Apr 30, 2026, 10:42The Link Between Lifestyle and Anti-Müllerian Hormone – RBMO
